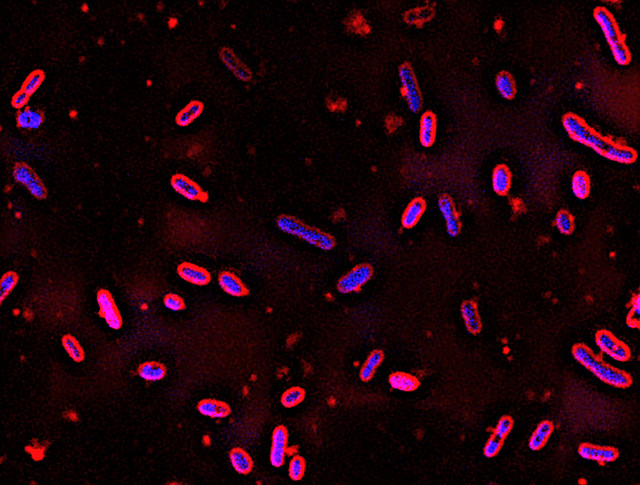
Novosphingobium aromaticivorans (Image GLBRC)

A genetically modified bacterium could allow a leap forward in the production of biodegradable plastics
An article published in the journal “Green Chemistry” describes the possibility of using bacteria of the species Novosphingobium aromaticivorans to produce a plastic material starting from wood processing waste following some genetic modifications. A team of researchers worked on this bacterium, which in nature can already digest many parts of lignin, improving its ability to produce a substance known as PDC on which bioplastic materials are already based upon but with production difficulties that could be overcome using these bacteria.

